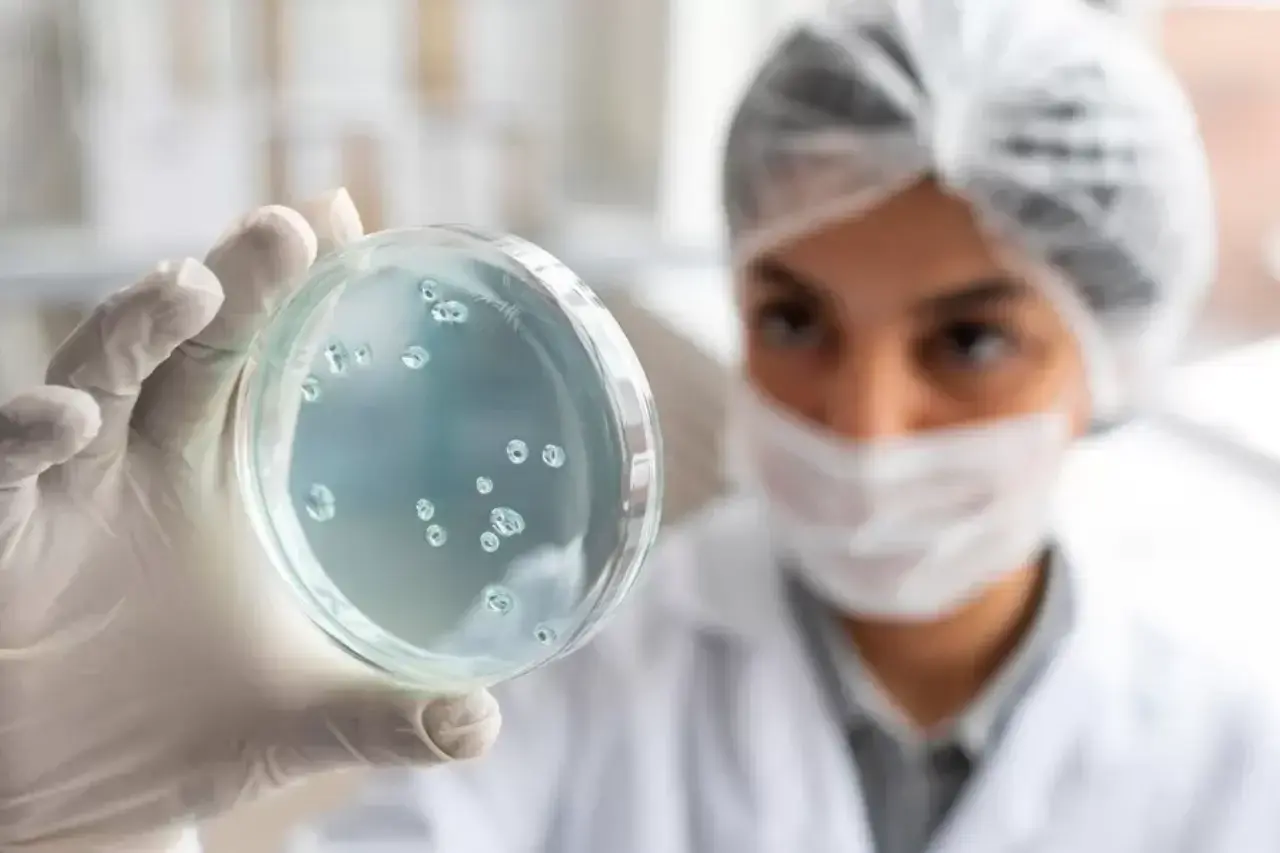

В Таджикистане зафиксирован рост случаев передачи заболеваний от животных людям.
Число подобных случаев возросло, но летальных исходов зафиксировано не было, сообщил заместитель начальника Государственной службы санитарно-эпидемиологического надзора республики Навруз Джафаров.
По его словам, уровень заболеваемости в стране в течение всего года находился под контролем, и, кроме роста случаев зоонозных заболеваний, существенных изменений в динамике других болезней не наблюдается.
Николай Ильясов